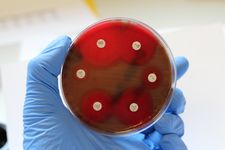

Research
Contact
Director
Office at Klinikum Oldenburg
Address
Research
The research of the Medical Microbiology working group is primarily concerned with antibiotic and antimycotic resistance, as well as its detection and dissemination. Bacterial pathogens with resistance to certain antibiotics are increasing in frequency, which is why early and accurate detection of resistance mechanisms is essential for effective treatment and prevention of further spread. For this reason, the working group is working, among other things, on the detection of resistant or multi-resistant germs and the optimization of various diagnostic test procedures.
Another focus is on the spread of resistance genes and plasmids with resistance genes in bacterial populations. Whole genome sequencing and short read/long read sequencing can be used to investigate the spread of resistance genes over time and identify possible interventions. The influence of various factors on the ability of bacteria to exchange genetic material - and thus possibly resistance genes - is also being investigated.
In order to gain a comprehensive understanding of the spread of resistance genes, we also work with veterinarians as part of One Health projects and isolate pathogens from environmental samples. This makes it possible to track how pathogens and resistance spread not only in small populations, such as in a hospital, but also how practices in animal husbandry, agriculture and healthcare interact and contribute to the spread of pathogens. The aim is to understand the spread of resistance genes and to find a holistic concept for intervention.